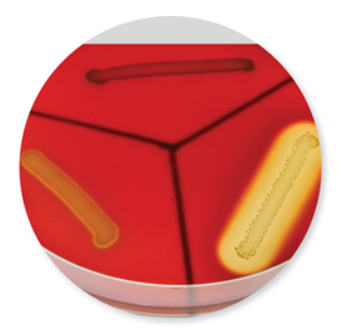

Properly order the four stages of clinical infection.
Rank the options below.
A) Incubation period
B) Acute phase
C) Convalescent period
D) Prodromal stage
A) Incubation period
D) Prodromal stage
B) Acute phase
C) Convalescent period
Explanation: The incubation period starts when the microbe and host first come in contact and ends at the appearance of the first symptoms. The first symptoms are often general feelings, such as fatigue and aches. During the period of invasion, the microbe is multiplying at its highest levels, exhibiting virulence, and causing specific damage to target tissues. The symptoms begin to decline and the patient’s health returns during the convalescent period.
Review the figure to answer the question below.
Which of the following may be members of the holobiont?
A) Pathogens
B) Transient microbes
C) Resident microbes
D) All of these may be members of the holobiont at some point.

D) All of these may be members of the holobiont at some point.
Review the figure to answer the question below.
True or False: Colonization will result in infection and disease if any pathogenic microbes are present.
A) True
B) False

B) False
Explanation: Potential pathogens can simply exit the body without multiplying and causing infection.
Review the figure to answer the question below.
True or False: You may not always know you have been colonized by a microbe, but you will always know if it proceeds to an infection.
A) True
B) False

B) False
Explanation: Many infections go unnoticed because they are asymptomatic!
Review the figure to answer the question below.
Which of the following may be the result of colonization with a pathogenic microbe?
Check All That Apply
A) The pathogen does not attach to the host well and is cleared by the host.
B) The pathogen may multiply and cause infection, leading to possible disease.
C) The pathogen may reside as part of the resident microbiota in low numbers.
D) The pathogen must be cleared entirely from the body or it will lead to disease.
E) The presence of the pathogen will result in signs and symptoms that can be clinically diagnosed.

A) The pathogen does not attach to the host well and is cleared by the host.
B) The pathogen may multiply and cause infection, leading to possible disease.
C) The pathogen may reside as part of the resident microbiota in low numbers.
Which of the following are virulence factors?
Multiple Choice
A) Toxins
B) Enzymes
C) Capsules
D) All of the choices are correct.
D) All of the choices are correct.
Explanation: All of these may increase the virulence of a pathogen by allowing them to invade host tissues, evade the host immune system, or cause damage to host tissues.
Order the following steps a microorganism takes in the process of establishing disease.
Rank the options below.
A) Microbe enters through its portal of entry.
B) Microbe overcomes host defenses.
C) Disease is established.
D) Microbe attaches to receptor on host.
A) Microbe enters through its portal of entry.
D) Microbe attaches to receptor on host.
B) Microbe overcomes host defenses.
C) Disease is established.
Explanation: First, the microbe must gain entry to the host through its portal of entry. Once in (or on) the host, the microbe attaches to receptors. It then manages to evade the host’s defenses. Once it has overcome or neutralized the host’s defenses, it can begin to cause pathology and disease is established.
The best descriptive term for the resident microbiota is
Multiple Choice
A) pathogenic.
B) commensal.
C) parasitic.
D) mutualistic.
D) mutualistic.
Explanation: Resident microbiota are helpful to the human host in a variety of ways, one being the protection of the host through microbial antagonism and another, the synthesis of needed nutrients such as vitamin K.
Most microbial exotoxins would be created using the process of:
Multiple Choice
A) DNA replication.
B) fatty acid synthesis.
C) mutation.
D) transcription and translation.
D) transcription and translation.
Explanation: Exotoxins are proteins made through the process of transcription of DNA to mRNA and then translation to an amino acid sequence.
All infectious diseases are also communicable.
Multiple Choice
A) True
B) False
C) Need more information
B) False
This person had hepatitis A and recovered from the illness. However, individuals continue to harbor the virus for several years. If this individual does not practice appropriate safety measures at a job, patrons of the restaurant may become ill. This individual would then represent a:
Multiple Choice
A) incubation carrier.
B) asymptomatic carrier.
C) passive carrier.
D) chronic carrier.

D) chronic carrier.
Explanation: Many patients who recover from hepatitis will carry the infectious agent chronically. They can pass it unknowingly to others because they are a chronic carrier.
This is an image of a blood agar plate after inoculation and incubation. What chemical is being produced by the bacteria on the lower right side of the plate?
Multiple Choice
A) Endotoxin
B) Hemolysin
C) Coagulase
D) Streptokinase
Explanation: Hemolysins disrupt the cell membranes of red blood cells in the agar, resulting in distinct, clear zones around the bacterial growth. Hemolysins include the streptolysins and the alpha and beta toxins of Staphylococcus aureus, important virulence factors for these organisms.
Exotoxins are:
Multiple Choice
A) proteins secreted by living bacterial cells.
B) antiphagocytic factors.
C) lipopolysaccharides.
D) secretions that always target nervous tissue.
E) only released after a cell is damaged or lysed.
A) proteins secreted by living bacterial cells.
Animals that participate in the life cycles of pathogens and transmit pathogens from host to host are:
Multiple Choice
A) mechanical vectors.
B) aerosols.
C) droplet nuclei.
D) biological vectors.
E) fomites.
D) biological vectors.
The relative ability of a microbe to establish itself in a host and cause disease is referred to as:
Multiple Choice
A) virulence.
B) exogenous.
C) variance.
D) opportunism.
A) virulence.
Local edema, swollen lymph nodes, fever, soreness, and abscesses are indications of:
Multiple Choice
A) inflammation.
B) sequelae.
C) a syndrome.
D) latency.
E) toxemia.
A) inflammation.
True or False: Septicemia means that a pathogen is present and multiplying in the blood.
A) True
B) False
A) True


